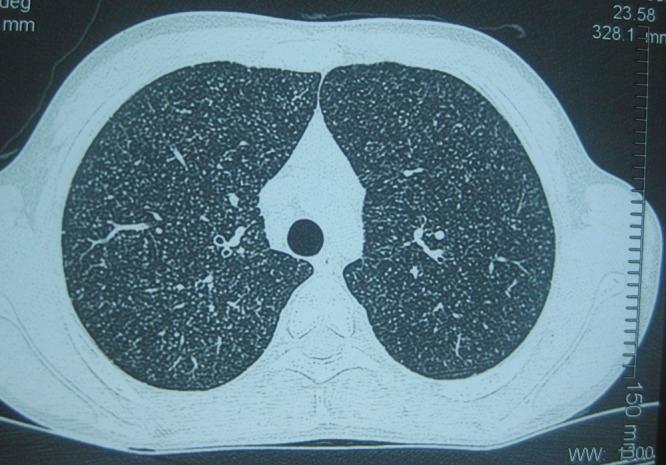

Persistent Fever and Skin Lesions Due to Histoplasmosis in a Boy from Rural Nepal.
作者信息
Thapa Shovit, Jha Sunil Chandra, Trotter Andrew B
出版信息
Am J Trop Med Hyg. 2016 Feb;94(2):249-250. doi: 10.4269/ajtmh.15-0664.
Abstract
摘要
相似文献
1
Persistent Fever and Skin Lesions Due to Histoplasmosis in a Boy from Rural Nepal.
Am J Trop Med Hyg. 2016 Feb;94(2):249-250. doi: 10.4269/ajtmh.15-0664.
2
Cutaneous histoplasmosis.
Am Rev Respir Dis. 1976 May;113(5):689-93. doi: 10.1164/arrd.1976.113.5.689.
3
Cutaneous histoplasmosis disclosing an HIV-infection.
An Bras Dermatol. 2013 May-Jun;88(3):420-3. doi: 10.1590/abd1806-4841.20131812.
4
Pathologic quiz case: A persistent cutaneous eruption in a human immunodeficiency virus-infected man.
Arch Pathol Lab Med. 2001 Apr;125(4):571-2. doi: 10.5858/2001-125-0571-PQCAPC.
5
Histoplasmosis.
Semin Dermatol. 1993 Dec;12(4):310-4.
6
[Clinical comparative analysis for pulmonary histoplasmosis and progressive disseminated histoplasmosis].
Zhong Nan Da Xue Xue Bao Yi Xue Ban. 2016 Dec 28;41(12):1345-1351. doi: 10.11817/j.issn.1672-7347.2016.12.016.
7
Disseminated cutaneous histoplasmosis in an immunocompetent child, relapsed with itraconazole, successfully treated with voriconazole.
Pediatr Dermatol. 2010 Sep-Oct;27(5):549-51. doi: 10.1111/j.1525-1470.2010.01273.x. Epub 2010 Aug 26.
8
[Cutaneous Histoplasmosis and AIDS].
Gac Med Mex. 2003 May-Jun;139(3):270-5.
9
Disseminated cutaneous histoplasmosis in HIV infection.
J Assoc Physicians India. 2012 Aug;60:43.
10
If It Looks Like a Duck, Swims Like a Duck, and Quacks Like a Duck--Does It Have to Be a Duck?
PLoS Negl Trop Dis. 2016 Apr 28;10(4):e0004430. doi: 10.1371/journal.pntd.0004430. eCollection 2016 Apr.
引用本文的文献
1
Paediatric Histoplasmosis 2000-2019: A Review of 83 Cases.
J Fungi (Basel). 2021 Jun 4;7(6):448. doi: 10.3390/jof7060448.
本文引用的文献
1
Histoplasma capsulatum: more widespread than previously thought.
Am J Trop Med Hyg. 2014 Jun;90(6):982-983. doi: 10.4269/ajtmh.14-0175. Epub 2014 Apr 28.